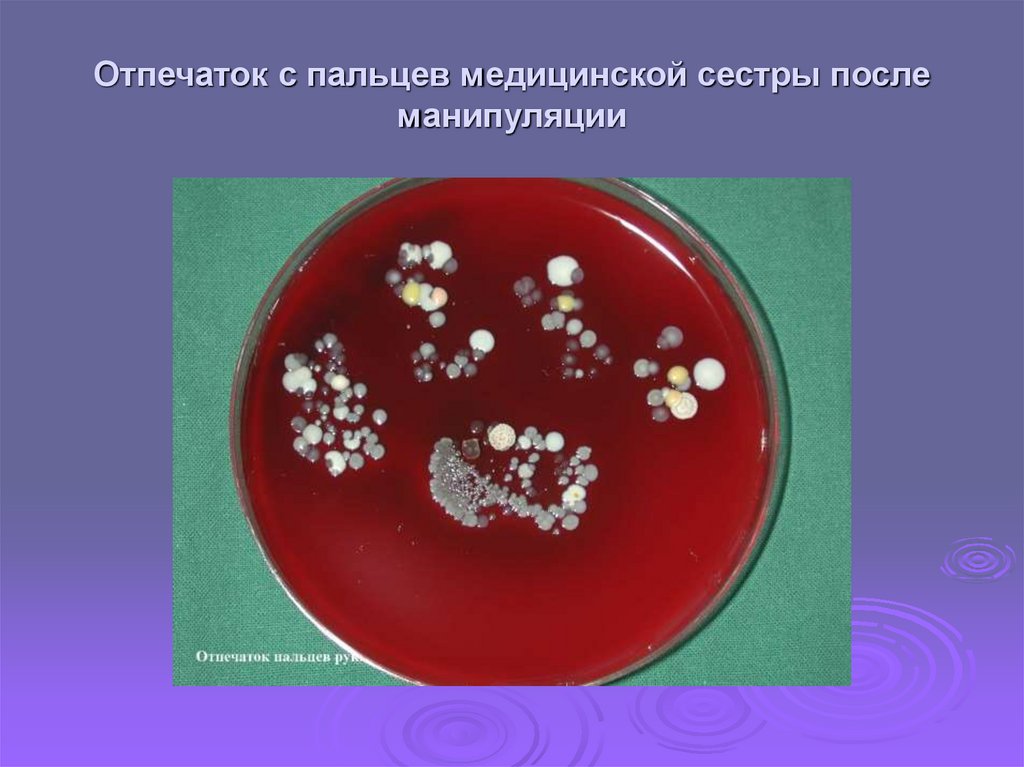
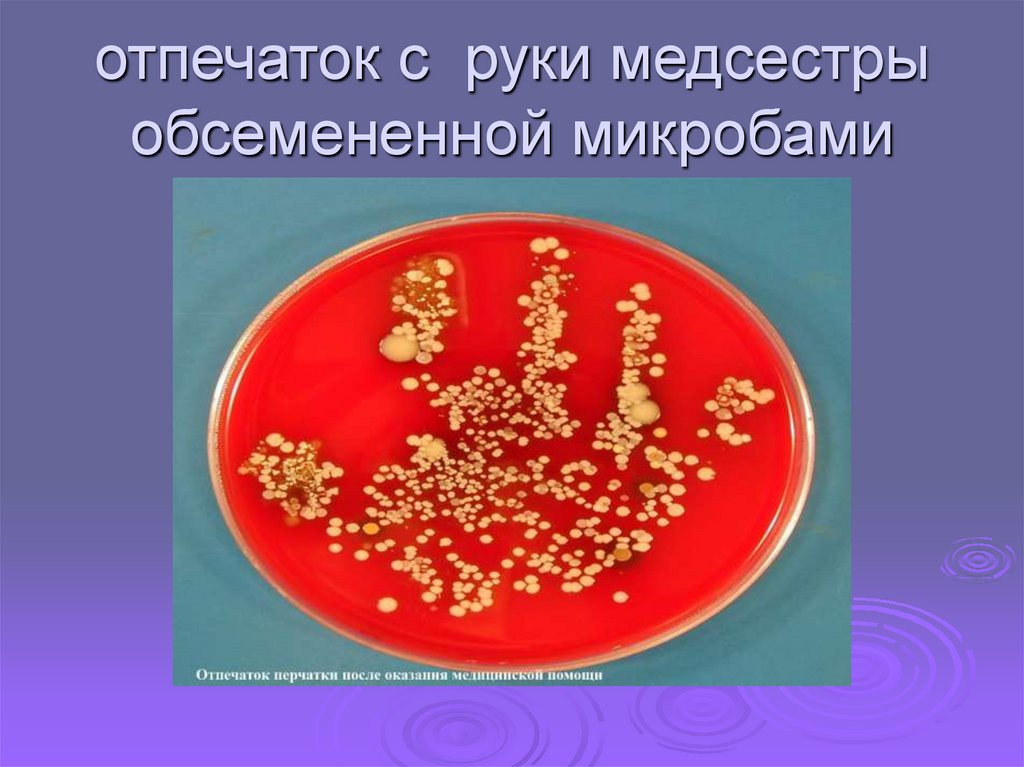
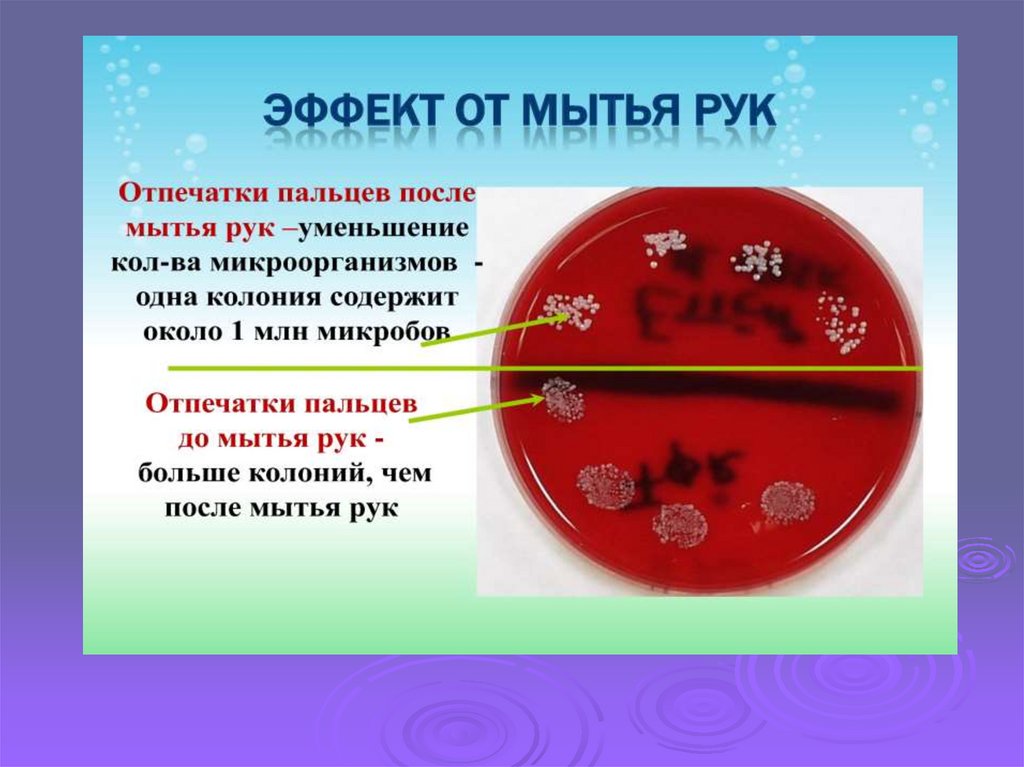
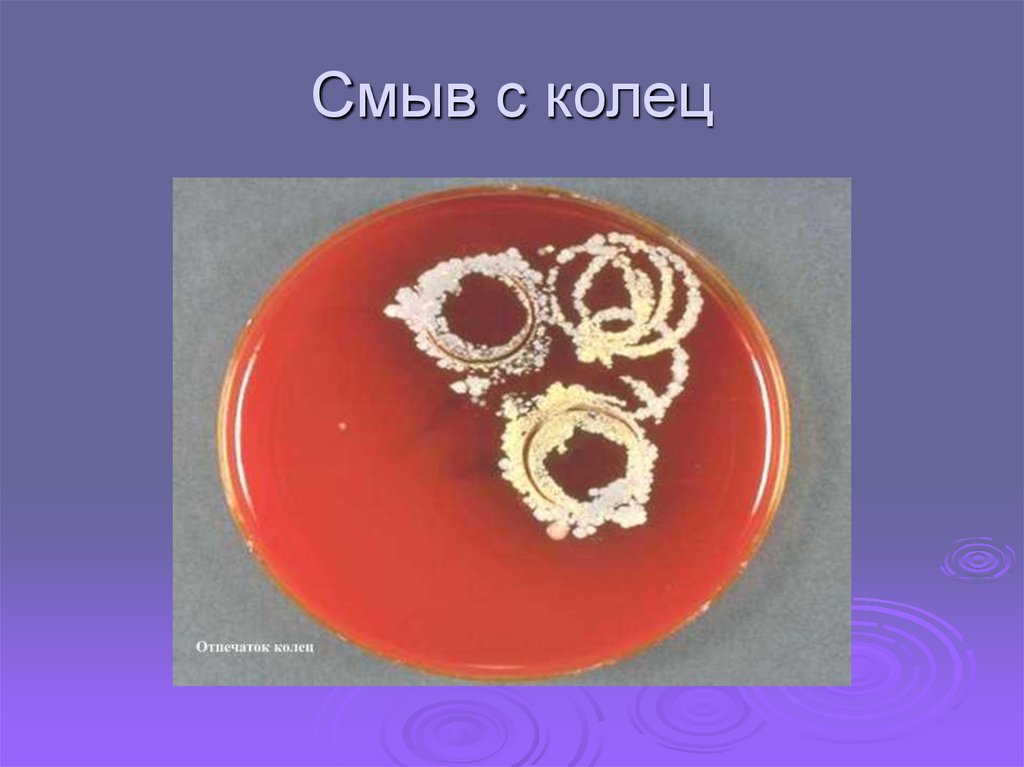
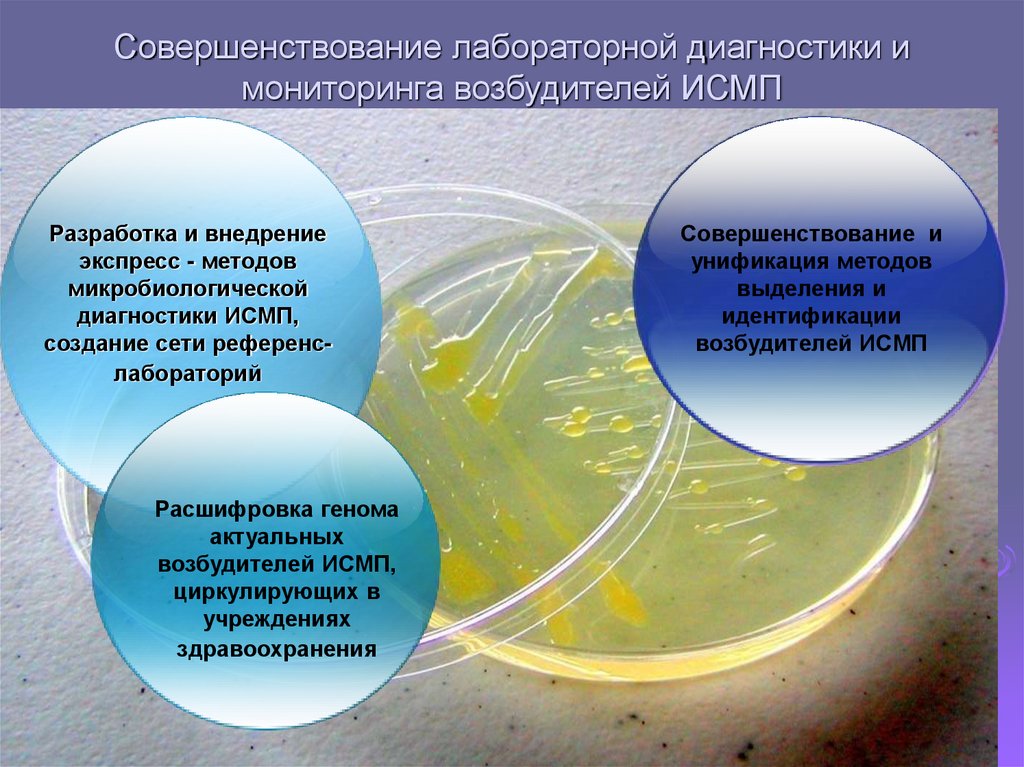

Похожие презентации:
ИСМП (Инфекции, связанные с оказанием медицинской помощи)
1.
ИСМП2.
«Начала общей военно-полевой хирургии»Н.И. Пирогов
Если я оглянусь на кладбище, где
схоронены зараженные в госпиталях, то
не знаю, чему больше удивляться:
стоицизму ли хирургов или доверию,
которым продолжают пользоваться
госпитали у правительства и общества.
Можно
ли
ожидать
истинного
прогресса, пока врачи и правительства
не выступят на новый путь и не
примутся
общими
усилиями
уничтожать источники госпитальных
миазм.
3.
Стратегической задачей здравоохранения являетсяобеспечение качества медицинской помощи и создание
безопасной среды пребывания для пациентов и персонала
в организациях, осуществляющих медицинскую
деятельность. Инфекции, связанные с оказанием
медицинской помощи (ИСМП), являются важнейшей
составляющей этой проблемы в силу широкого
распространения, негативных последствий для здоровья
пациентов, персонала и экономики государства.
4.
Термин «инфекция, связанная с оказаниеммедицинской помощи» (Healthcare associated infection (HAI), являясь более
точным, в настоящее время используется
как в научной литературе, так и в
публикациях ВОЗ и нормативных
документах большинства стран мира.
5.
Эволюция терминаЯтрогенные
инфекции
(Iatrogenic
infections)
Послеоперационные
инфекции
Госпитальные
инфекции
(Surgical
infections)
Нозокомиальные
инфекции
(Hospital infections)
(Nosocomial
infections)
Внутрибольничные
инфекции
(Hospitalacquired
infections)
ИСМП
(Healthcareassociated
infections)
* Garner, J. S. CDC definition for nosocomial infections, 1988 / J. S. Garner, W. R. Jarvis, T. G. Emori, T. C. Horan, J. M. Hughes // Am. J. Infect. Control. – 1988. – Vol.16. – P.128-140.
Horan, T. C. CDC/NHSN surveillance definition of health care-associated infection and criteria for specific types of infections in the acute care setting / T. C. Horan, M. Andrus, M. A.
Dudeck // Am. J. Infect. Control. – 2008. – Vol. 36. – P. 309-332.
McKibben, L. Guidance on Public Reporting of Healthcare-Associated Infections: Recommendations of the Healthcare Infection Control Practices Advisory Committee / L. McKibben, T.
Horan, J. I. Tokars [et al.] // Am. J. Infect. Control.- 2005. – Vol.33. – P.217-226
Parker, M.T. Hospital-acquired infections: guidelines to laboratory methods. - Copenhagen, World Health Organization, Regional Office for Europe (European Series, No. 4), 1978.
Simpson, R. A. Hospital infection // Medical Microbiology. A Guide to Microbial Infections: Pathogenesis, Immunity, Laboratory Diagnosis and Control. Ed. By D. Greenwood, R. Slack, J.
Peutherer. - 15th Ed. - Edinburgh: Churchill Livingstone, 1997. – P.644-689.
WHO/CDS/CSR/EPH/2002.12 Prevention of hospital-acquired infections. A practical guide.// www.who.int.emc - 2nd edition./edd. G.Ducel, J. Fabry, L. Nicolle – WHO, 2002. Description
of the contents
6.
Со времени признания существованияинфекций связанных с оказанием медицинской
помощи не найдено универсальное решение
этой проблемы. Более того, в связи со
стремительным развитием медицинской науки
и техники, происходит новый виток этой
группы заболеваний, охватывающей все
отрасли медицины и все типы медицинских
учреждений.
7.
Инфекции, связанные с оказанием медицинскойпомощи, поражают 5-10% пациентов,
находящихся в стационарах, и занимают
десятое место в ряду причин смертности
населения. В России по данным официальной
статистики ежегодно регистрируется примерно 30
тыс. случаев инфекций, связанных с оказанием
медицинской помощи (≈ 0,8 на 1000 пациентов),
однако эксперты считают, что их истинное число
составляет не менее 2-2,5 млн. человек.
8.
Инфекции, связанные с оказаниеммедицинской помощи – случаи инфекции
связанные с оказанием любых видов медицинской
помощи (в медицинских стационарных и
амбулаторно-поликлинических, образовательных,
санаторно-оздоровительных учреждениях,
учреждениях социальной защиты населения, при
оказании скорой медицинской помощи, помощи
на дому и др.), а также случаи инфицирования
медицинских работников в результате их
профессиональной деятельности.
9.
Факторы, влияющие на возникновение ИСМПБиологические :
- Эволюция возбудителя с
изменением его биологических
свойств под влиянием прессинга
применяемых лекарственных
препаратов, а именно: формирование
и широкое распространение
полирезистентных к антибиотикам
штаммов условно-патогенных
микроорганизмов, отличающихся
высокой вирулентностью и
повышенной устойчивостью к
факторам внешней среды в т.ч. к
дезинфектантам.
10.
Медико – организационные:- возрастание числа сложных инвазивных методик
обследования и лечения, способствующих
миграции возбудителя в организм больного;
- частое использование терапевтических средств,
подавляющих иммунную систему;
- нарушение санитарно- гигиенического и
противоэпидемического режимов.
11.
Демографический- увеличение удельного веса лиц старшего возраста
- увеличение числа лиц, относящихся к
контингентам повышенного риска: больные
хроническими заболеваниями, недоношенные
новорожденные и др.
12.
Факторы, способствующиеИСМП
Увеличение
Снижение защитный
«агрессивности
сил населения.
Создание
медицинских
»
Нарушение
санитарного
комплексов
с высокой
Увеличение
числа
противоэпидемического
плотностью
контингента
пациентов
с и
Бесконтрольное
применение
режима.
мед.
персонала.
нераспознанными
антибиотиков,
иммунодепрессантов,
инфекциями,
со стертыми
дезинфицирующих
средств.
формами инфекции
13.
Источники ИСМППациент
Медицинские
Технический
Посетители
Родственники
Студенты
персонал
работники
14.
Механизмы, пути и факторыпередачи ИСМП.
Механизмы
Путь передачи
Факторы
Аэрогенный
Воздушно-капельный,
воздушно-пылевой
Кондиционеры,
вентиляционная
система.
(аэрозольный)
Фекальнооральный
Контактный
Контактно-бытовой
пищевой
Контактнобытовой(прямой,
косвенный)
Трансмиссивный
Руки мед. персонала и
пациентов
Прием пищи,
приготовленный
снаружи
Инфекция, передающаяся
половым путем
Через руки, инструменты
Живой переносчиккровососущие, насекомые.
15.
Цепочка инфекционного процессаВОЗБУДИТЕЛЬ
РЕЗЕРВУАР
СПОСОБ
ПЕРЕДАЧИ
ВЫХОДНЫЕ
ВОРОТА
ВХОДНЫЕ ВОРОТА
ИНФЕКЦИИ
ВОСПРИИМЧИВЫЙ
ХОЗЯИН
16.
ЭТИОЛОГИЯ ИСМПИСМП - полиэтиологичные заболевания.
Обширный перечень возбудителей ИСМП
включает представителей различных
таксономических групп, относящихся к
бактериям, вирусам, простейшим и грибам.
17.
Наиболее распространенныевозбудители ИСМП:
Бактерии
•Стафилококки
•Стрептококки
•Синегнойная палочка
•Энтеробактерии
•Эшерихии
•Сальмонеллы
•Шигеллы
•Иерсинии
•Листерии
•Кампилобактерии
•Легионеллы
•Клостридии
•Неспорообразующие
анаэробные бактерии
•Микоплазмы
•Хламидии
•Микобактерии
•Бордетеллы
Вирусы
•Вирусы гепатита B,
C, D
•ВИЧ
•Вирусы гриппа и
других ОРВИ
•Вирус кори
•Вирус краснухи
•Вирус
эпидемического
паротита
•Ротавирус
•Энтеровирусы
•Норволк-вирусы
•Вирус герпеса
•Цитомегаловирус
Простейшие
•Пневмоцисты
•Токсоплазмы
•Криптоспоридии
Грибы
•Кандида
•Аспергиллы
•Гистоплазмы
18.
Возникновение резистентности - естественныйбиологический процесс!
ЭЙ, парень! Хочешь
быть
«супермикробом»?
Возьми-ка эту штуку
для своего генома!
Даже пенициллин не
причинит тебе вреда!
19.
Бактерии имеют оружие даже против несуществующихпрепаратов?
Бактерии признаны «ultimate pathogens» (совершенными
патогенами) по причине экстраординарной приспособляемости их пластичность и способность к выживанию не имеют границ
20.
Механизм резистентности - изменение в геномеВозможные способы обмена генами
между бактериями:
• с помощью вирусов
• внехромосомных плазмидных ДНК
• просто через ДНК
Гигантский арсенал выбора противодействия
антибиотикам: бактериальных геномов- более
20 тыс. генов резистентности 400 различных типов!!!
21.
Этиология ИСМПВнутрибольничные инфекции могут быть обусловлены
огромным числом микроорганизмов (около 300 видов),
относящихся к различным таксономическим группам.
Среди возбудителей инфекций связанных с оказанием
медицинской помощи лидируют бактерии, с которыми
связано около 90% всех ИСМП. Большинство из них
могут образовывать биопленки, что способствует их
выживанию во внешней среде.
22.
Считают, что до 60% случаев ИСМП связано собразованием бактериальных биопленок на
медицинской аппаратуре и различных
поверхностях, бесспорна их роль при инфекциях,
связанных с имплантацией. В биопленке бактерии
окружены биополимерным матриксом,
продуцируемым самими бактериями.
Антибиотики медленнее проникают в биопленки.
Внутри них бактерии в известной мере защищены
от воздействия антибиотиков. Биопленки играют
роль и в персистенции некоторых видов бактерий.
23.
Устойчивость микроорганизмов, в частности условнопатогенных, к антибактериальной терапии некоторые ученыесвязывают с образованием особых форм бактерий,
находящихся в состоянии метаболического покоя – так
называемых клеток – персистеров (Lewis K., 2010)
Роль покоящихся форм установлена:
в персистенции возбудителя туберкулёза (Hu & Coates,2003;
Zhang, 2005);
в патогенезе катетер-ассоциированных инфекций (Lewis K.,
2012);
-при пневмонии, ассоциированной с муковисцидозом;
-легионеллёзе (Maarten Fauvart et al . 2011).
24.
Клетки персистерыТОЛЕРАНТНЫ К АНТИБИОТИКАМ
В СОСТАВЕ БИОПЛЕНОК НЕДОСТУПНЫ ДЛЯ
АНТИТЕЛ И КЛЕТОК ИММУННОЙ СИСТЕМЫ
ОБРАЗУЮТСЯ ПРИ ОКИСЛИТЕЛЬНОМ СТРЕССЕ
НАКАПЛИВАЮТСЯ В ПРОЦЕССЕ
ИММУННОДЕПРЕССИВНЫХ ВОЗДЕЙСТВИЙ
25.
БактерииБольшинство бактериальных агентов, обуславливающих
возникновение ИСМП, принадлежат к условно
патогенным микроорганизмам. Среди них доминируют
90%
- стафилококки (золотистый, эпидермальный)
- грамотрицательные бактерии (энтеробактерии,
псевдомонады), синегнойная палочка, протей, клебсиелла
В качестве этиологических агентов выступают
стрептококки групп А и В, энтерококки, возбудители
брюшного тифа, шигеллы, сальмонеллы, коринебактерии
дифтерии, микобактерии туберкулеза.
26.
При попадании в организмхозяина микроорганизм не
обязательно вызывает
инфекцию. Он может
существовать и
размножаться, не
повреждая при этом ткани
и не вызывая иммунного
ответа у хозяина (это
состояние называется
колонизацией)
27.
Способность микроорганизма вызыватьинфекцию различной степени тяжести
зависит от:
инфицирующей дозы;
способности прикрепляться к поверхности клеток
хозяина
и размножаться;
способности продуцировать токсины;
способности подавлять иммунную систему хозяина.
28.
ИСМП вызывают, как правило,госпитальный штамм (ГШ) возбудителя. Он
формируется вследствие адаптации к
условиям стационара, в первую очередь,
приобретая полирезистентность к
антимикробным препаратам, применяемым
в конкретной клинике и высокую
вирулентность.
29.
Повышение вирулентности является главным иведущим признаком госпитального штамма.
Ослабленный больной, получив такой штамм,
заболевает быстрее, чем при заражении менее
вирулентным штаммом и быстрее становится его
распространителем.
30.
Из гетерогенной популяции микроорганизмовнаиболее благоприятные условия для отбора
получают самые вирулентные штаммы.
Они, длительно пассируясь на ослабленных
больных, становятся все более вирулентными, при
этом одновременно происходит отбор по
резистентности к антимикробным препаратам.
Через определенный период времени
формируется истинно госпитальный штамм.
31.
Госпитальный штамм - это штамм,который в процессе циркуляции
адаптировался к условиям стационара,
т.е. приобрел большие возможности к
паразитированию, специфичному для
больных данного стационара и вызвал
не менее двух случаев клинически
выраженных заболеваний.
32.
33.
Выявлена множественная лекарственнаяустойчивость возбудителей ИСМП к
антибиотикам, химиопрепаратам.
Установлено, что для штаммов с множественной
лекарственной устойчивостью, выделенных от
больных ИСМП, у кишечной палочки колеблется
в пределах 30-35%, у синегнойной палочки - 4050%, у клебсиелл и энтеробактера достигает 7075%.
34.
Около 40% штаммов микобактерий туберкулезаустойчивы к препаратам, используемым в арсенале
средств лечения и экстренной профилактике инфекции.
35.
У госпитального штамма наблюдаетсяформирование более высокой устойчивости к
воздействию факторов окружающей среды:
высушиванию, действию УФО,
дезинфицирующих препаратов
при заниженных концентрациях дезинфектантов
возбудители могут не только сохраняться, но и
размножаться.
36.
Учитывая современные научные знания имедицинские технологии , часть инфекций
связанных с оказанием медицинской помощи
предотвратить невозможно.
Поэтому наши усилия должны быть направлены
на улучшение системы оказания медицинской
помощи посредством активизации
эпидемиологического надзора.
Улучшения материального обеспечения и методик
антимикробных средств
37.
Разработка эффективных диагностическихи лечебных процедур
Охрана здоровья медицинского персонала
38.
ежегодное диспансерное обследование медицинскогоперсонала с исследованием крови на ВИЧ - инфекцию,
сифилис, маркеры ВГВ и С;
флюорография органов грудной клетки;
осмотр врачей - специалистов;
специфическая иммунопрофилактика ряда инфекций
(гепатит В, дифтерия, корь).
39.
40.
41.
Отпечаток с пальцев медицинской сестры послеманипуляции
42.
отпечаток с руки медсестрыобсемененной микробами
43.
44.
45.
46.
47.
Кольца — этокрасиво, но не так
безопасно, как
кажется. Под
кольцом на
вашем пальце
могут жить около
730 млн
микробов.
48.
Смыв с колец49.
50.
Совершенствование лабораторной диагностики имониторинга возбудителей ИСМП
Разработка и внедрение
экспресс - методов
микробиологической
диагностики ИСМП,
создание сети референслабораторий
Расшифровка генома
актуальных
возбудителей ИСМП,
циркулирующих в
учреждениях
здравоохранения
Совершенствование и
унификация методов
выделения и
идентификации
возбудителей ИСМП

Медицина
Медицина








